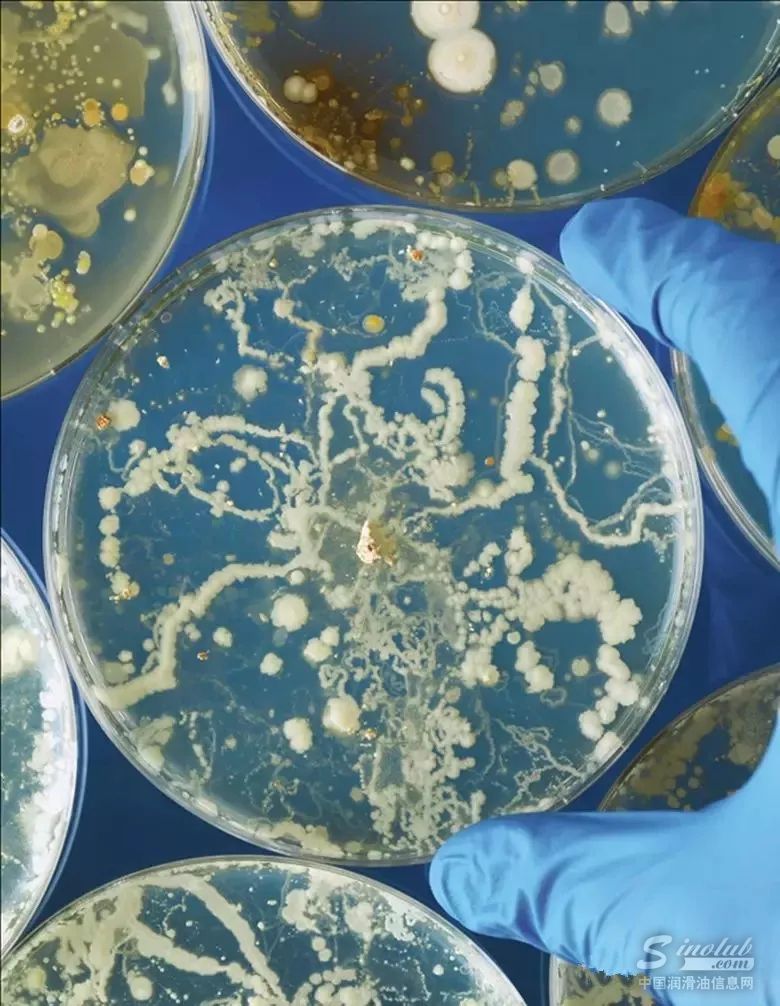

金属加工液微生物学的研究与水性金属加工液的发展同时兴起,水性金属加工液也称水溶性、乳化性或不正确的水溶性流体。尽管第一篇有关这一主题的论文《切削液中细菌的性质、生长和控制研究》于1941年发表,但直到十年后才开始持续专注进行研究。
Ratul Shah及Robert Donofrio于2012年发表论文,据说是为了审阅金属加工液微生物学过往和当前的知识状况,但并无提及E.O. Bennet,其是第一位将金属加工液微生物学当作终生研究的生物学家。1954年至1991年间,他发表了170篇有关这个主题以及相关健康风险的论文。
在不了解Bennett所作的贡献——在线文献搜索不容易发现这一点——或不了解大量现有的金属加工液微生物学知识的情况下,许多年轻的研究人员、实验室技术员和流体管理人员或更有可能报告“发现”,而这些“发现”只是证实了几十年前首次报告的结果。要做的进一步研究仍非常多,花时间重新学习先前建立的科学将是对有限资源的浪费。
金属加工液微生物学具有77年历史,可分为四个阶段,每个阶段跨幅一二十年。对这段历史的简要总结引出了尚未探索的研究问题,这些问题将为金属加工液的未来发展提供方向。

起源(1950年至1970年)
20世纪50年代初,随着水溶性金属加工液的销量增长,Texaco的技术人员开始提出疑问,暴露在稀释金属加工液中的机械师是否会因致病微生物而增加患病概率。该公司联系了当时在休斯顿大学担任博士后研究员的Ed bennett,并资助了他最初的金属加工液微生物学研究。
同样,近十年后,Master Chemical的联合创始人兼首席执行官Clyde Sluhan聘请底特律韦恩州立大学(Wayne State University)的副教授Harold Rossmoore调查与暴露在水溶性金属加工液致病微生物中的工作人员有关的风险。
当时,所有水溶性金属加工液均为可乳化油。尽管Bennett、Rossmoore以及其他研究人员从正在使用的金属加工液和稀释它们的水中定期检测到潜在致病菌,但他们发现微生物检测和疾病频率之间没有关系。因此,有关这一时期对使用水溶性金属加工液的机械师是否更容易微生物感染的答案是否定的。

生物腐蚀的重点研究(1970年至1990年)
直至1927年清洁水法案将已用金属加工液列为有害垃圾,金属加工液生物腐蚀不成问题。在操作人员开始积极监测和控制微生物污染之前,他们通常会在8到12周后丢弃已用的金属加工液,最常见的原因是异味,而机械零件上的闪光腐蚀是更换金属加工液的另一个重要原因。
20世纪70年代早期的研究表明,不受控制的微生物污染导致了水溶性金属加工液的性能失效。尽管恶臭的气味是最常见的问题,但维持pH值、乳化稳定性和腐蚀抑制的难度增加与微生物的数量有关,其数量大于每十分之一毫升就有一百万至一千万个菌落形成单位(在经过孕育处理的培养试验桨上形成的红点)。

在这个时期,许多生物杀灭剂制造商也将其产品注册用于金属加工液。1970年至1990年间,超过90%的生物杀灭剂活性成分进入市场,而生物杀灭剂被视为增值产品。这种看法与20世纪80年代初流体管理同时产生。
到20世纪80年代末,系统转储之间的一般维护周期从一个季度增加到一年以上。管理得当的系统能够运行数年而无需排水、清洗和充电。虽然不受控制的微生物污染不是唯一相关的失效机制,但它通常被认为是金属加工液失效的常见主要原因。金属加工液微生物研究重点是生物杀灭剂性能和替代使用策略。这项工作的补充是改进配方以延长性能寿命。
重新审视健康影响(1990年至2000年)
1992年,一家汽车零部件厂的许多工人被诊断为过敏性肺炎,这是对微生物过敏反应造成的肺部疾病。这一事件引起了人们对金属加工液微生物研究的浓厚兴趣。
1992年至2000年期间,整个金属加工行业报道了约250个HP病例。而不变的是,HP是群发疾病,在某一工厂中就有四到四十个病例。从金属加工液中回收的超过12种不同类型的细菌和真菌会诱发HP。
然而,Rossmoore在一次工业卫生会议上的推测性评论导致许多利益相关者将注意力集中到一种微生物:抗酸分支杆菌免疫原体。至少有一家大型汽车制造商根据Rossmoore的错误理论禁用了常用的生物杀灭剂,即所谓的快速生长细菌(在48小时内产生可见菌落的细菌)抑制了分支杆菌免疫原体的生长,而使用生物杀灭剂抑制了微生物的快速生长,从而使分支杆菌免疫原体有可能生长。

十年后,Harold Rossmoore的遗孀Katalin Rossmoore和儿子Leonard Rossmoore以及我合作进行了一项研究,证明了其他微生物的存在或缺失与分支杆菌免疫原体的存在没有联系。很明显,一旦分支杆菌免疫原体的检测成为常规微生物状况检测的一部分,微生物便是一种常见的金属加工液污染物。
结果表明,在历史上,当使用培养皿或培养浆进行培养并观察至少一个星期,并且只有在不存在快速生长微生物的情况下,才能看到分支杆菌免疫原体菌落。除非培养基中含有抑制快速生长的细菌的抗生素,否则在分支杆菌免疫原体形成之前,它就长满其他微生物群落。专注分支杆菌免疫原是对无视数据危险的极好案例研究,这些数据是不可避免的结果。
除了以HP为重点的研究,许多论文还指出了金属加工液雾(也称为内毒素暴露)与呼吸功能间的关系。内毒素是细菌细胞壁的重要组成部分,根据它们对革兰氏染色剂的阴性反应分类(因此得名革兰氏阴性细菌)。尽管样品测定和分析技术都没有标准化,研究人员报告了金属加工液和金属加工液气雾剂的内毒素浓度。

在几项研究中,报告的空气传播内毒素浓度与美国国家职业安全与健康研究所的研究人员先前所报道的中毒性休克综合症有关。然而,在检测到高内毒素含量(每立方米超过7000毫克)的设施中,过敏或工业哮喘的发生率与检测到内毒素含量不足100毫克的设施没有什么不同。
在千年之交,人们普遍认为,接触生物气溶胶(空气微生物)是过敏性疾病的原因,从轻微眼部疼痛和咽喉肿痛(过敏性鼻炎)到可能致命的工业哮喘和HP。关于如何最好地控制生物气溶胶形成的具体事项仍存在相当大的分歧,但人们普遍同意减少雾暴露的总量将降低疾病风险。整个20世纪90年代,机器外壳和喷雾收集系统越来越普遍。到2000年,雾气遏制和控制成为行业常态。并非巧合的是,呼吸系统疾病患病率直线下降,人们对生物气溶胶的研究和监测兴趣几乎消失殆尽。
现今(2000年至今)
本世纪伊始,金属加工液生物腐蚀
再次成为微生物研究的热点。
1998年实施的欧洲议会生物杀灭剂指令对金属加工液杀微生物剂的使用造成一定压力。自此,根据欧洲化学品管理局(European Chemicals Agency)的数据,欧盟现有可用的杀微生物剂数量已从180多种减少至27种活性物质。

相似地,ASTM International指出,获美国批准用于金属加工液的杀微生物剂名单已缩减至不足50种。可用的杀微生物剂减少促进了抗生物金属加工液添加剂和成品配方的发展。
为了绕过监管问题,一些配方设计师正在使用未注册为生物杀菌剂、但在配方中没有其他作用的有毒化学品。人们可能会思考,使用这些流体是否会带来意想不到的健康风险。一般来说,合成金属加工液比半合成或乳化油配方更不敏感。确定其中的原因仍然是无法满足的研究需求。
展望未来
还有其他一些重要但尚未解决的金属加工液微生物研究需求。行业利益相关者需要制定一致的方法收集和分析生物气溶胶样品。如果在20世纪90年代获得的内毒素数据是准确的,我们需要了解农业工作者暴露在内毒素中和疾病发生的关系为什么在机械师中不存在。如果过往的数据不准确,我们需要更好地了解实际暴露情况。
微生物产生微生物挥发性有机化合物。许多微生物挥发性有机化合物是属过敏性或有毒的。然而,到目前为止,还没有关于使用金属加工液的设施中微生物挥发性有机化合物浓度的研究报告。
流体管理者开始认识到生物膜控制对整个微生物污染控制的重要性。生物膜是动态的微生物群落,它生长在复杂粘滑的物质中,称为细胞外聚合物。然而,对于金属加工液系统中生物膜群落的取样或测试还没有一致的方法。
近期,基因工具已经被用来描述金属加工液中的微生物群落特征。基因检测可以检测到许多传统的培养基测试方法无法测试到的微生物。这些资料有助于更深入地了解种群大小及其多样性;通常,不同类型的微生物协同工作,比单一类型的微生物会导致更严重的生物腐蚀。

展望未来,代谢组学检测将会揭示在受污染系统中基因被激活,而微生物却在制造问题的情况。这类研究有望在生物废物处理过程中寻找更经济、环境友好的策略防止金属加工液生物腐蚀和加速生物降解。
这些新的研究方向
很可能揭示出我们还没有想过的问题。
作者:FREDERICK J. PASSMAN
更多资讯,欢迎扫描下方二维码关注中国润滑油信息网微信公众号(sinolub)
作为世界500强,加拿大石油拥有丰厚的油砂矿资源,经营着世界上最大的基础油精炼厂之一,调配并包装生产出多种润滑油成品。
南京东沛国际贸易集团有限公司(DU-HOPE INTERNATIONAL GROUP)是一家成立于1978年的专业外贸企业,注册资金3900万元。
北京龙润凯达石化产品有限公司成立于2001年,是中国北方地区润滑油基础油销售量最大的贸易企业。